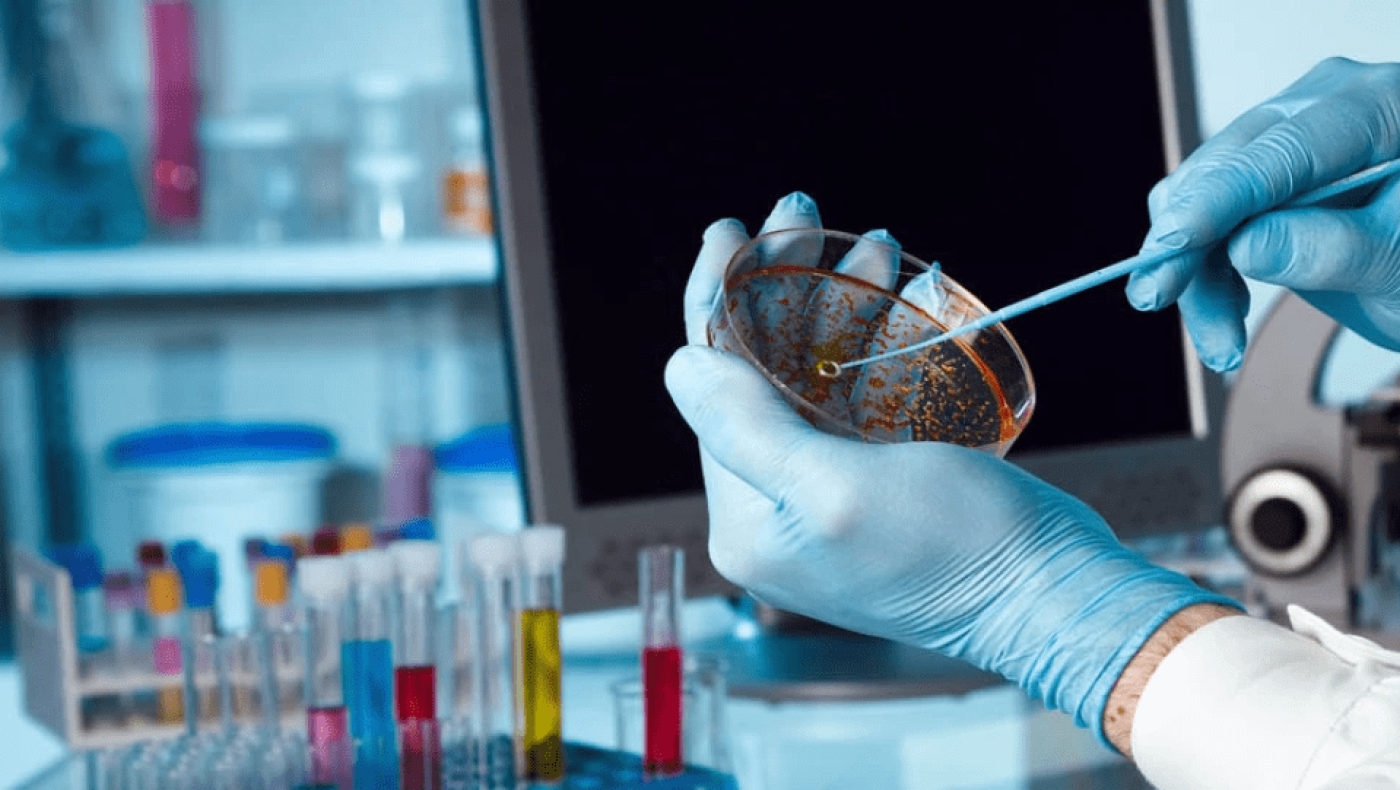
Τεστ αίματος εντοπίζει 50 είδη καρκίνου πριν την εμφάνιση συμπτωμάτων

Τεστ αίματος εντοπίζει 50 είδη καρκίνου πριν την εμφάνιση συμπτωμάτων
Η Εθνική Υπηρεσία Υγείας (NHS) της Βρετανίας αρχίζει σήμερα την μεγαλύτερη δοκιμή παγκοσμίως της αιματολογικής εξέτασης Galleri της Grail Inc, η οποία μπορεί να χρησιμοποιηθεί για τον εντοπισμό περισσότερων από 50 ειδών καρκίνου πριν από την εμφάνιση συμπτωμάτων.
Το τεστ Galleri εξετάζει το DNA στο αίμα ενός ασθενούς για να εξακριβώσει αν στοιχεία του προέρχονται από καρκινικά κύτταρα. Η έγκαιρη διάγνωση των καρκίνων οδηγεί σε σημαντικά αυξημένα ποσοστά επιβίωσης.
Η NHS ανακοίνωσε ότι θέλει να στρατολογήσει 140.000 εθελοντές στην Αγγλία για να εξετάσει πόσο καλά λειτουργεί το τεστ στο πλαίσιο μιας τυχαιοποιημένης δοκιμής ελέγχου. Στους μισούς από τους μετέχοντες θα ελέγχεται αμέσως το δείγμα αίματός τους με το τεστ Galleri.
«Χρειάζεται να μελετήσουμε το τεστ Galleri προσεκτικά για να δούμε αν μπορεί να μειώσει σημαντικά τον αριθμό των καρκίνων των οποίων η διάγνωση γίνεται σε προχωρημένο στάδιο», δήλωσε ο Πίτερ Σασιένι, καθηγητής πρόληψης του καρκίνου στο King’s College του Λονδίνου.
«Το τεστ θα μπορούσε να αλλάξει τους κανόνες του παιγνιδιού στην έγκαιρη ανίχνευση του καρκίνου και είμαστε ενθουσιασμένοι που ηγούμαστε αυτής της σημαντικής έρευνας», πρόσθεσε.
Ο καρκίνος του πνεύμονα είναι μακράν η πιο συνηθισμένη αιτία θανάτου από καρκίνο στη Βρετανία, καθώς αναλογεί στο ένα πέμπτο όλων των θανάτων από την επάρατη νόσο.
Οι καρκίνοι του πνεύμονα, των εντέρων, του προστάτη και του μαστού αναλογούν στο 45% των θανάτων από την νόσο αυτή στο Ηνωμένο Βασίλειο, σύμφωνα με την NHS.
Η αμερικανική εταιρεία βιοεπιστημών Illumina Inc ανακοίνωσε τον περασμένο μήνα ότι ολοκλήρωσε την εξαγορά της Grail ύψους 7,1 δισεκατομμυρίων δολαρίων. Η Illumina πρόσθεσε ότι θα λειτουργεί την Grail ξεχωριστά από την τρέχουσα επιχείρησή της.
Ακολουθήστε τη σελίδα του metrosport.gr και στο google news.
Κάντε like στη σελίδα μας στο Facebook
ΣΧΕΤΙΚΑ ΑΡΘΡΑ
- Υποχρεωτικά διαγνωστικά test COVID-19 από 13/9/2021 έως 31/3/2022 για τις ομάδες πληθυσμού που δεν έχουν εμβολιαστεί
- Πνεύμονες: Η αδιόρατη αλλαγή που αυξάνει τον κίνδυνο αιφνίδιου καρδιακού θανάτου
- Χοληστερόλη: Η αλλαγή στα μάτια που προδίδει ότι έχει αυξηθεί
- Ταγίπ Ερντογάν: Χειροτερεύει η υγεία του –Ποιος θα τον διαδεχθεί;
